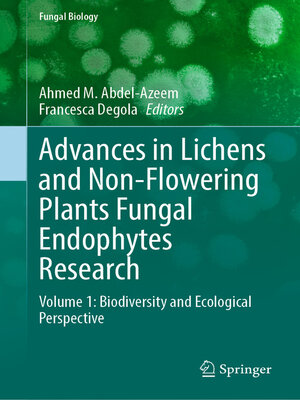

Springer Nature Switzerland
Sort
Filter
-
Subjects
- Nonfiction 13,098
- Computer Technology 3,995
- Technology 3,088
- Engineering 2,744
- Science 2,640
- Business 1,918
- Medical 1,345
- Sociology 1,303
- Management 1,297
- Politics 1,000
- Mathematics 913
- Education 734
- Reference 600
- Geography 558
- Psychology 525
- Philosophy 523
- History 510
- Nature 450
- Physics 374
- Psychiatry & Psychology 348
- Law 319
- Careers 287
- Art 255
- Language Arts 247
- Ethics 243
-
Creators
- Aleš Leonardis 89
- Elisa Ricci 89
- Gül Varol 89
- Olga Russakovsky 89
- Stefan Roth 89
- Torsten Sattler 89
- Beniamino Murgante 37
- Saumik Bhattacharya 36
- Umapada Pal 36
- Chiara Garau 35
- Osvaldo Gervasi 35
- Janusz Kacprzyk 33
- Ajith Abraham 30
- Apostolos Antonacopoulos 29
- Andreas Öchsner 28
- Kohei Arai 26
- Leonard Barolli 26
- Anu Bajaj 25
- Cheng-Lin Liu 22
- Liang-Jie Zhang 20
- A. K. Haghi 19
- Rama Chellappa 19
- Subhasis Chaudhuri 19
- Alessio Del Bue 17
- Artur Zaporozhets 16
-
Format
-
Imprint